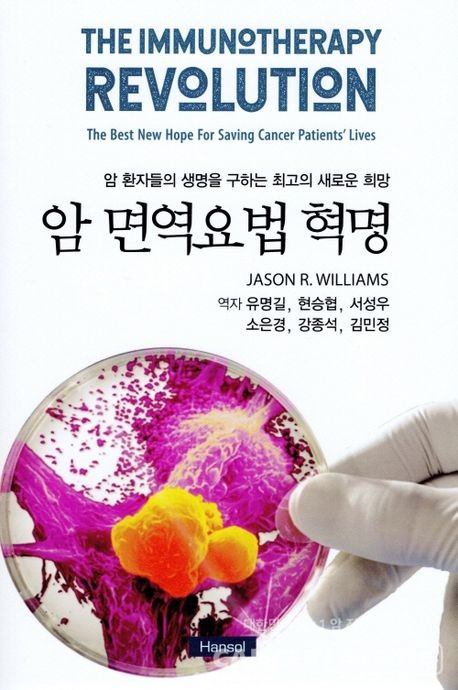
유명길 건강 컨설턴드 등 암 대사치료 카페 회원들이 함께 번역에 참여한 '암 면역요법 혁명' 번역판 표지.

면역항암제 사용 방법과 면역력을 높이는 방법을 상세히 알려주는 책 ‘암 면역요법 혁명’(제이스 윌리엄스 저) 한국어판이 출간됐다.
‘'암 대사치료 카페’ 회원(암환자, 보호자, 의료 전문가)인 유명길, 현승협, 서성우, 소은경, 강종석, 김민정씨가 함께 번역한 이 책은 방사선 전문의, 면역요법 전문의이자 냉동절제술과 종양 내 면역요법의 창시자인 제이슨 윌리엄스 박사가 썼다.
‘
암 면역요법 혁명’은 대표적인 면역항암제의 기전, 인체의 면역체계, 면역항암제의 효과 증진을 위한 방법, 기타 표준 치료와 면역항암제의 상호작용, 면역항암제 부작용 관리 뿐만 아니라 냉동절제술 및 종양 내 면역요법이라는 면역요법 분야의 신기술까지 다루고 있다.
번역에 참여한 현승협 삼성서울병원 핵의학과 교수는 “이 책은 면역요법의 핵심 원리와 관련된 여러 생물학적 기전들을 알기 쉽게 설명해 놓았으며, 면역항암치료의 혁명적인 발전 과정을 다루고 있다”고 소개했다.
암환자의 보호자로 번역에 참여한 서성우 씨(동의의료원 재활치료센터 물리치료사)는 “이 책에 언급된 근거 기반의 정보가 넘쳐나는 정보 속에서 환우와 가족들의 논리적 의사결정과 문제해결에 도움이 되었으면 한다”고 썼다.
암환자의 보호자로 ‘자연요법 종양학’을 번역했던 유명길 건강 컨설턴트는 "효과적인 암 치료와 재발관리를 위해서는 의료 전문가의 도움뿐만 아니라 환자 및 보호자의 공부 및 실천 그리고 서로 도울 수 있는 암경험자 커뮤니티의 도움이 절대적이라고 생각한다”며 “암치료에 주도권을 가지고 암을 극복하고자 노력하는 분들에게 작은 도움이라도 드리고 싶다”고 말했다.

